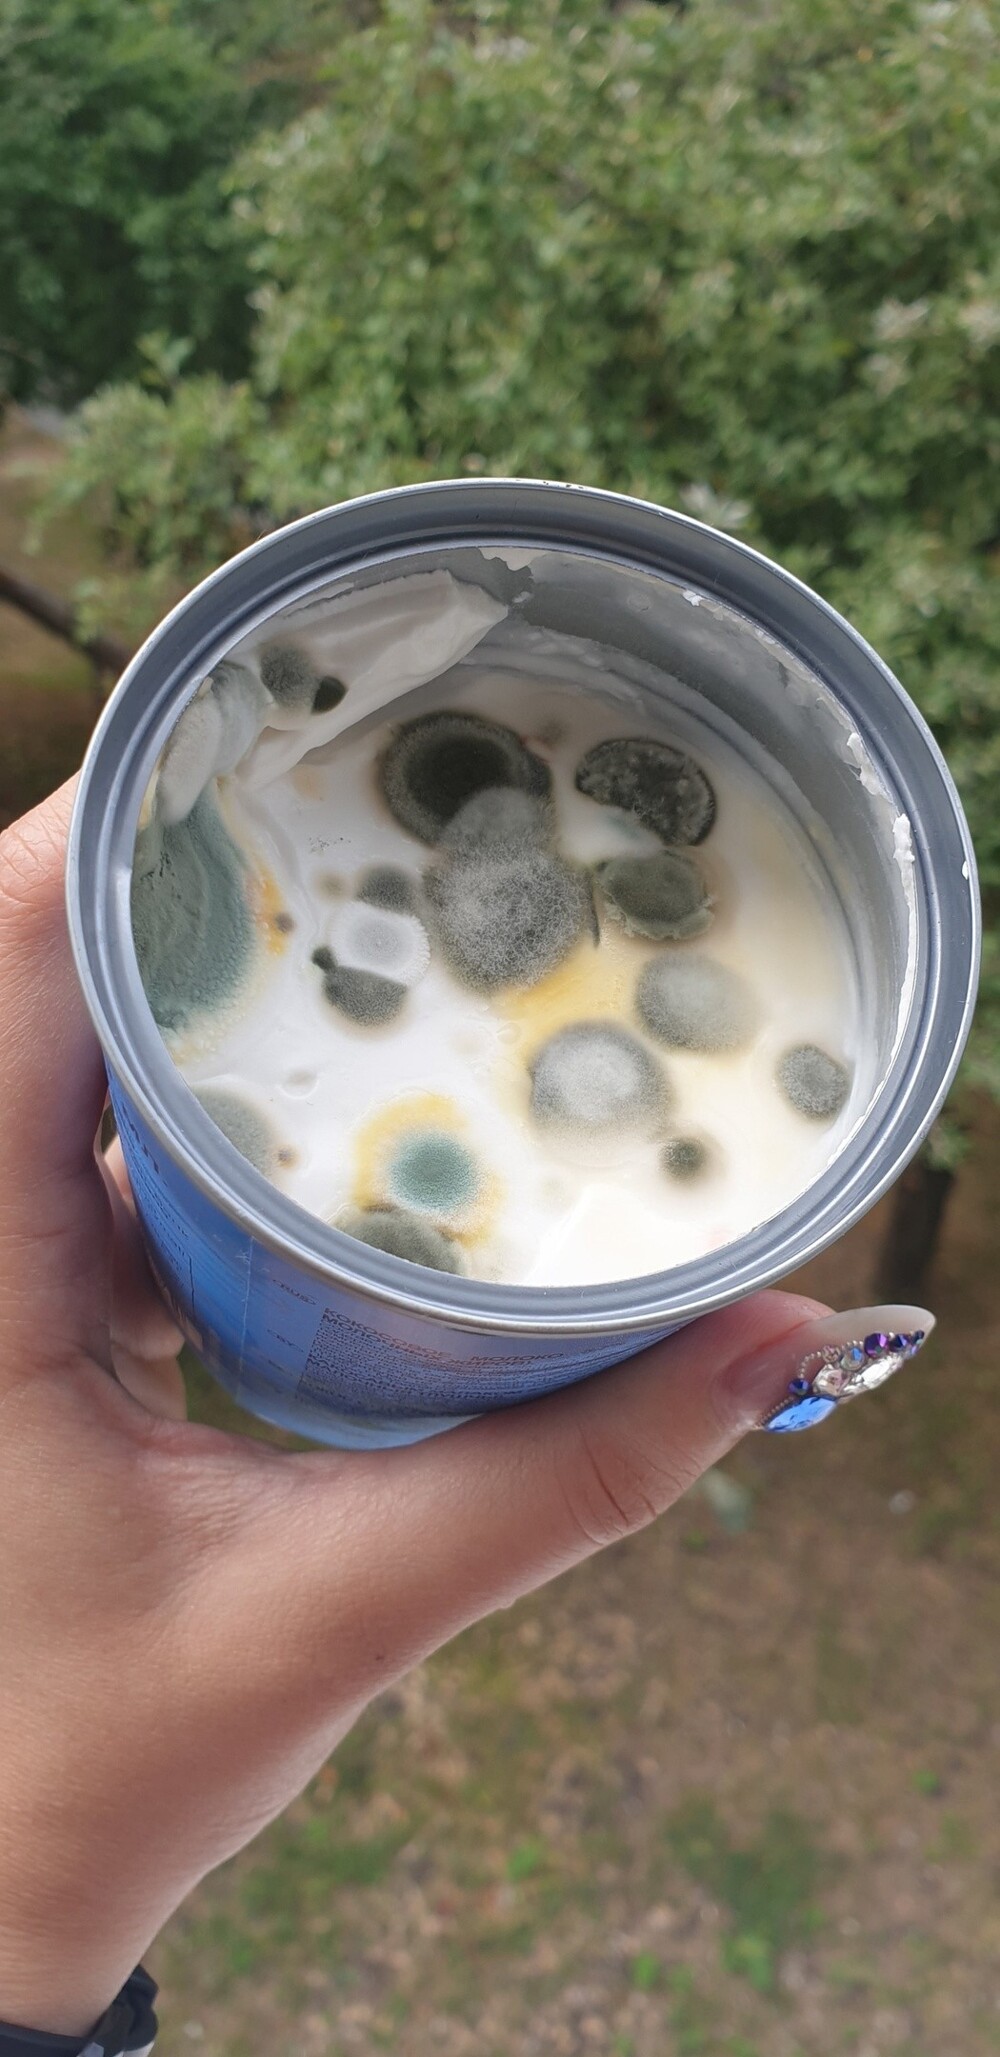

Иногда забывчивость играет злую шутку с людьми. Стоит ненадолго забыть о продуктах - и можно вырастить новую жизнь. Сегодня речь пойдёт о плесени! Вконтакте пользователи делятся, как им удалось вырастить цивилизации. 
1. Забытый на улице лимон напоминает какое-то произведение искусства 
2. "Мой папа смог вот такое чудо создать с помощью колбасы" 
3. Открытое кокосовое молоко выдержало недолго
4. Немного вяленого мяса с плесенью 
5. Микроорганизмы облюбовали лимон 
6. "В самолёте выдали яблоко, но я про нег забыла" 
7. Холодец отстоялся 
8. "Друг не доел, а мы забыли убрать - спустя неделю" 
9. Сыр фета, который один раз поели 
10. Ну очень сочные помидорки 
11. В чайнике завелась новая цивилизация 
12. Оказывается, быть творцом легко 
13. "Забыла про свой чай" 
14. Эх, варенье 
А вы когда-нибудь случайно выращивали плесень? Делитесь фото в комментариях!


















